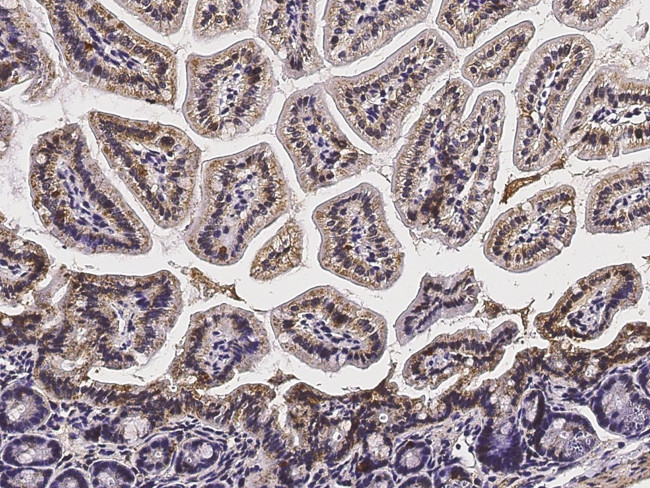
LAIR1 Antibody in Immunohistochemistry (Paraffin) (IHC (P))

Search
Invitrogen
LAIR1 Polyclonal Antibody
{{$productOrderCtrl.translations['antibody.pdp.commerceCard.promotion.promotions']}}
{{$productOrderCtrl.translations['antibody.pdp.commerceCard.promotion.viewpromo']}}
{{$productOrderCtrl.translations['antibody.pdp.commerceCard.promotion.promocode']}}: {{promo.promoCode}} {{promo.promoTitle}} {{promo.promoDescription}}. {{$productOrderCtrl.translations['antibody.pdp.commerceCard.promotion.learnmore']}}


Please note: We are reviewing Western blot images included in the antibody testing data in our catalog, including those provided by third parties. Unless expressly labeled or annotated as “raw-unedited”, Western blot images included in the antibody testing data in our catalog may have been edited, optimized or otherwise adjusted for presentation.
产品信息
PA5-81433
种属反应
宿主/亚型
分类
类型
抗原
偶联物
形式
浓度
规格
纯化类型
保存液
内含物
保存条件
运输条件
RRID
产品详细信息
This product is preservative free. It is recommended to add sodium azide to avoid contamination (final concentration 0.05%-0.1%).
This antibody has specificity for Mouse LAIR1.
靶标信息
CD305, also known as LAIR1, is a type I transmembrane glycoprotein with an extracellular Ig-like domain and two intracellular ITIMs. It is expressed on a wide range of immune cells, including T, NK, and B cells, monocytes, dendritic cells, eosinophils, basophils, and mast cells. In humans, CD305 is also present on CD34+ hematopoietic progenitor cells and thymocytes. Several isoforms exist due to alternative splicing, with expression varying between cell types. CD305 functions as an inhibitory receptor, playing a key role in regulating immune responses. It blocks cytokine-mediated signaling, cell proliferation, and apoptosis. In NK, B, and T cells, CD305 modulates cytolytic functions and cytokine production, down-regulating IL2 and IFNG in CD4+ T cells while inducing transforming growth factor beta. In B cells, it reduces IgG and IgE production and decreases IL8, IL10, and TNF secretion. Activation of CD305 through tyrosine phosphorylation recruits phosphatases PTPN6 and PTPN11, although it may also function independently of SH2-containing phosphatases. It inhibits differentiation of peripheral blood precursors into dendritic cells and has been shown to induce apoptosis in myeloid leukemia cell lines. Collagens are identified as ligands for CD305, underscoring its role in immune regulation.
仅用于科研。不用于诊断过程。未经明确授权不得转售。
篇参考文献 (0)
生物信息学
蛋白别名: CD305; LAIR-1; Leukocyte-associated immunoglobulin-like receptor 1
基因别名: 5133400O11Rik; BB115266; D7Bwg0421e; Lair-1; Lair1
UniProt ID: (Mouse) Q8BG84
Entrez Gene ID: (Mouse) 52855